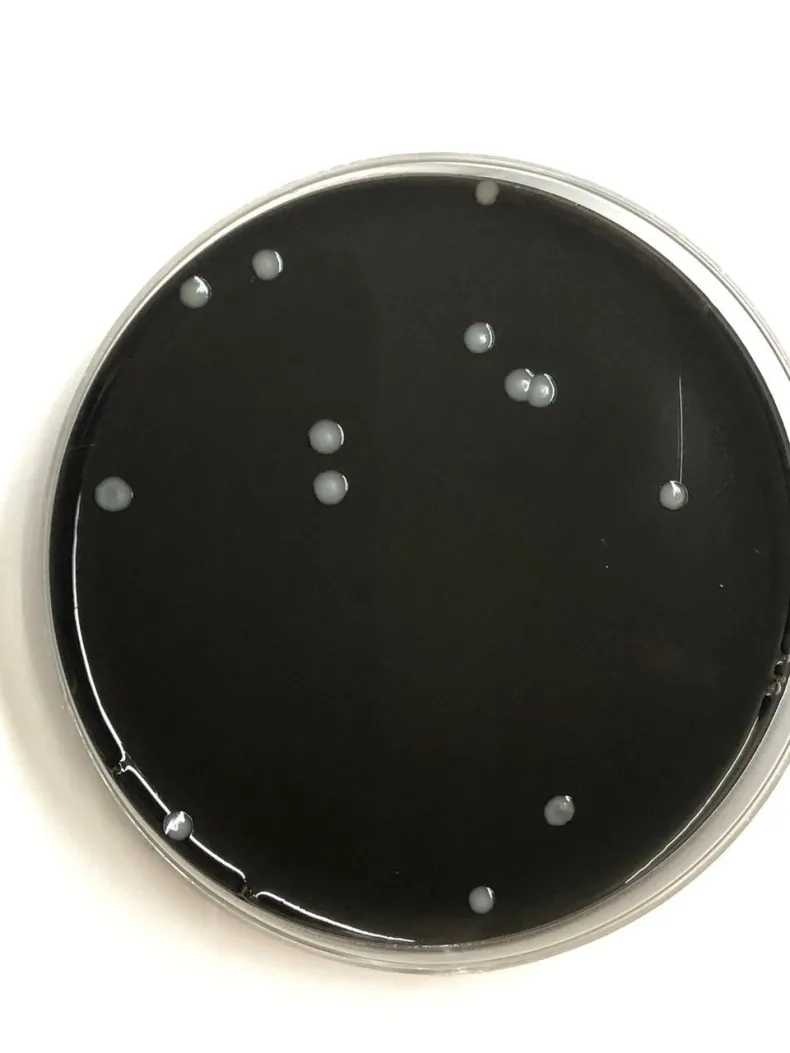

Periodista
Médico egresado de la UNNE investiga la presencia de bacteria peligrosa en tanques de agua domiciliarios
Francisco Marsilli, médico recibido en la Universidad Nacional del Nordeste, lidera un proyecto para detectar la bacteria Legionella spp., causante de la legionelosis, en tanques de agua de la ciudad de Resistencia y de Corrientes.

Pablo Francisco Marsilli Cóceres, de 25 años, se recibió de médico en diciembre de 2023 y obtuvo su título universitario en 2024. Actualmente, está finalizando un proyecto clave para detectar la presencia de la bacteria Legionella spp., responsable de la legionelosis, en tanques de agua domiciliarios de Resistencia y Corrientes. Esta bacteria, que puede causar graves infecciones pulmonares, como la Enfermedad del Legionario, suele proliferar en sistemas de agua mal mantenidos.
El proyecto, que Marsilli inició cuando aún era estudiante de Medicina en la Universidad Nacional del Nordeste (UNNE), está dirigido por la doctora Liliana Silvina Lösch. Según Lösch: "Nos hemos enfocado en la vigilancia de un microorganismo que se considera un patógeno emergente. A diferencia de otros, este no se transmite por consumo directo del agua, sino por inhalación, lo cual no está contemplado en las normativas nacionales". Este aspecto es crucial, ya que en Argentina no existen regulaciones específicas para controlar este tipo de microorganismos en el agua domiciliaria.
La legionelosis puede presentarse cuando las personas inhalan aerosoles que contienen la bacteria, y se puede encontrar en reservorios de agua mal mantenidos en lugares como hoteles, residencias de ancianos y hospitales. Según la Organización Mundial de la Salud, el 80% de las enfermedades humanas son transmitidas por agua contaminada,y la Legionella spp. es un claro ejemplo de patógeno que se transmite por inhalación.
En cuanto a la metodología, Francisco analizó 20 muestras de agua de tanques de almacenamiento, que fueron recolectadas en botellas estériles y trasladadas al laboratorio para su estudio. El joven investigador, becario del Consejo Interuniversitario Nacional (CIN), fue reconocido por sus avances en este proyecto, presentados en febrero de 2024, y recibió un premio en la reciente Reunión de Comunicaciones Científicas y Tecnológicas de la UNNE.
Lösch resaltó la importancia de su labor, afirmando: "Francisco está finalizando su beca, ya se recibió de médico, pero este proyecto sigue en curso. Se incorporó en el marco de un proyecto de vigilancia de Legionella, acreditado por la Secretaría General de Ciencia y Técnica de la UNNE".
Actualmente, Marsilli está en la etapa final del muestreo y presentó un informe que, si no requiere correcciones, será subido al sistema de investigación de la universidad.

